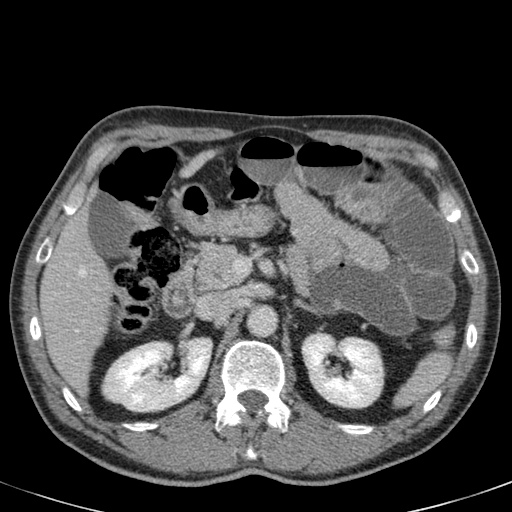
Slider image 6
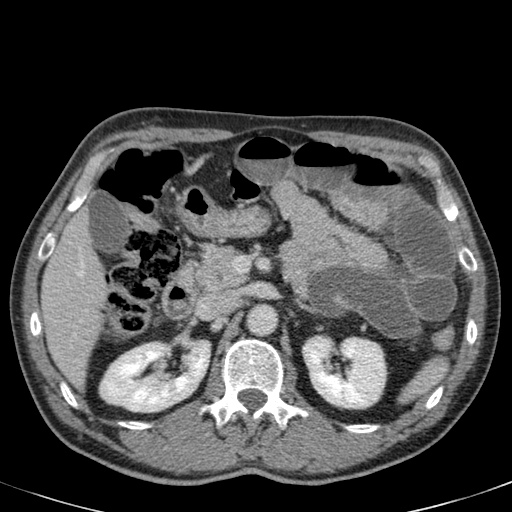
Slider image 7
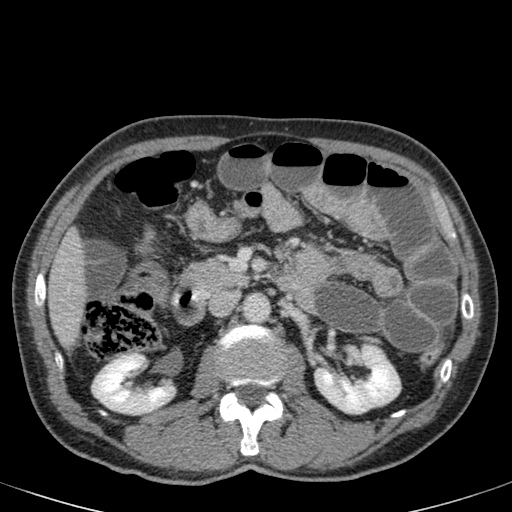
Slider image 13
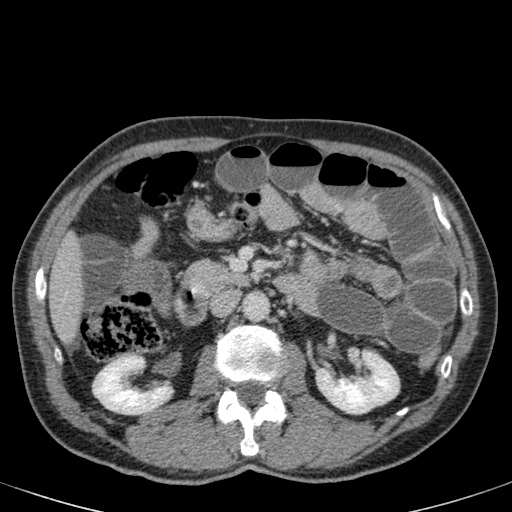
Slider image 14
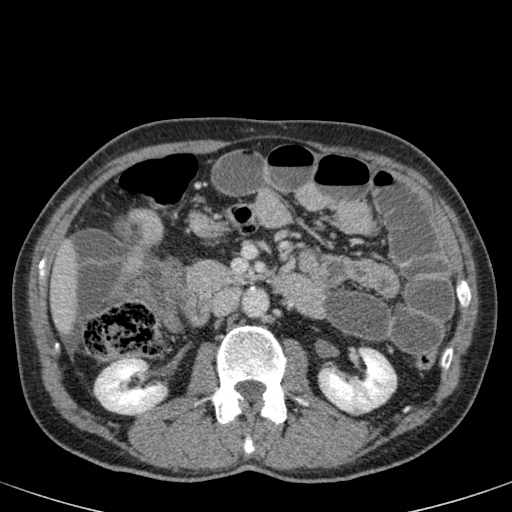
Slider image 16
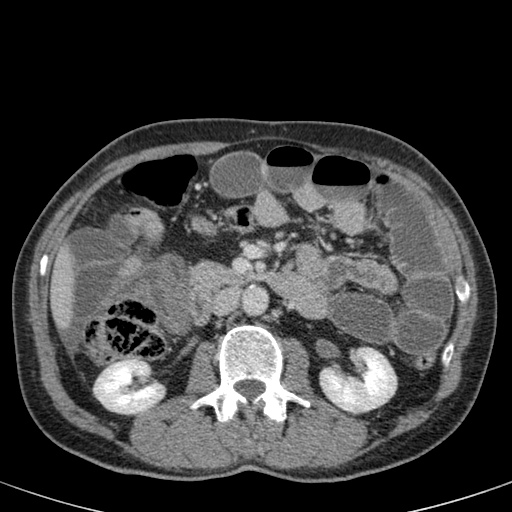
Slider image 17
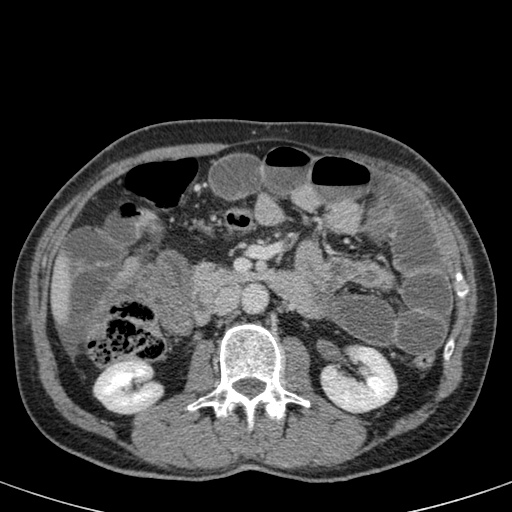
Slider image 18
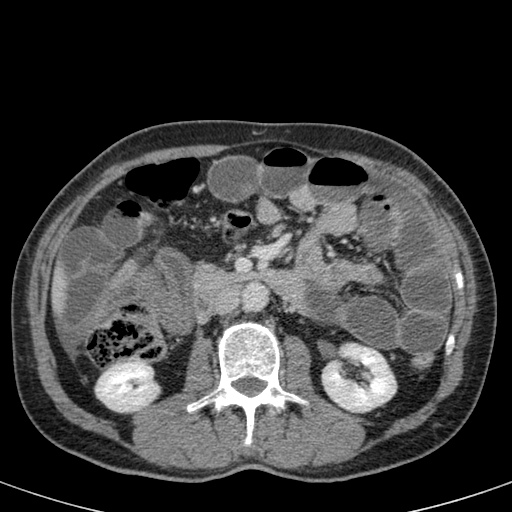
Slider image 19
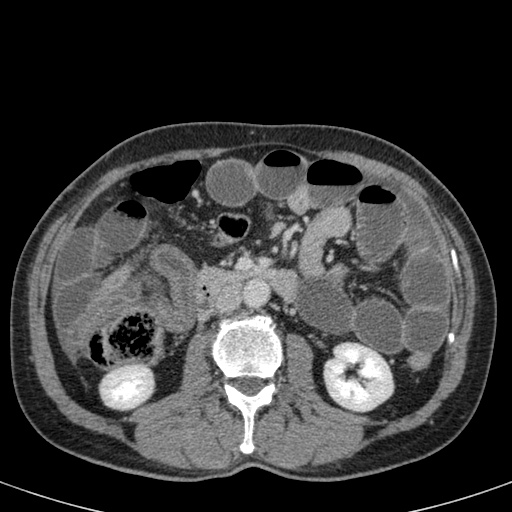
Slider image 20
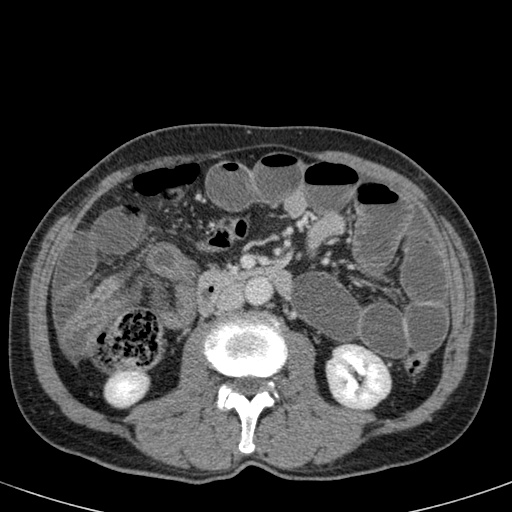
Slider image 22
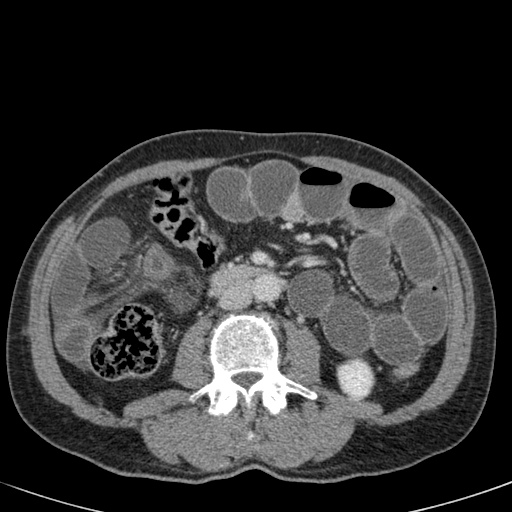
Slider image 27
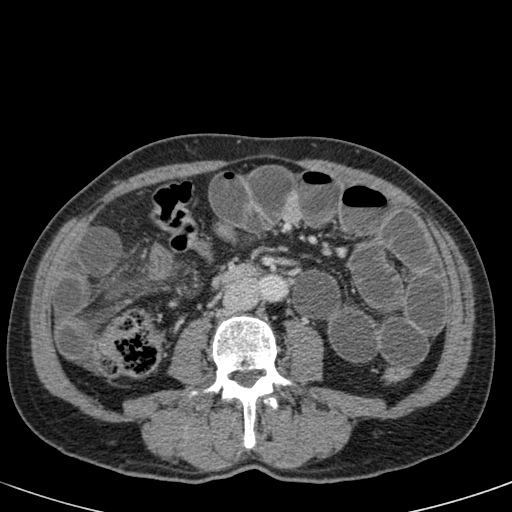
Slider image 30
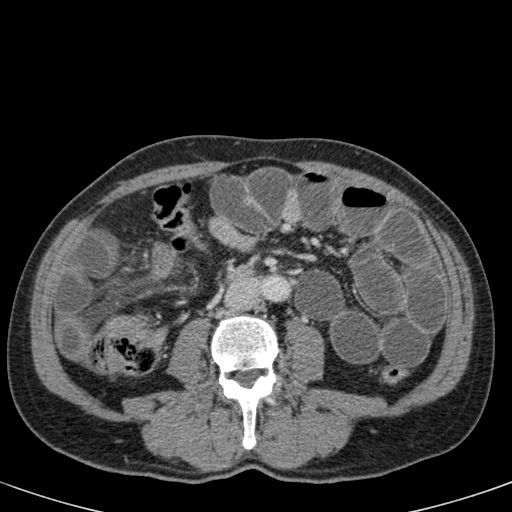
Slider image 31
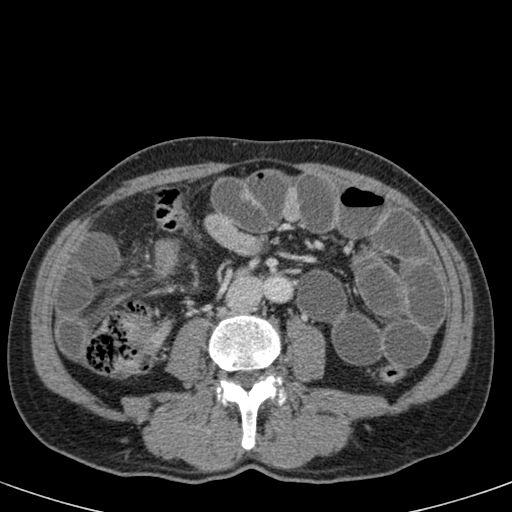
Slider image 32
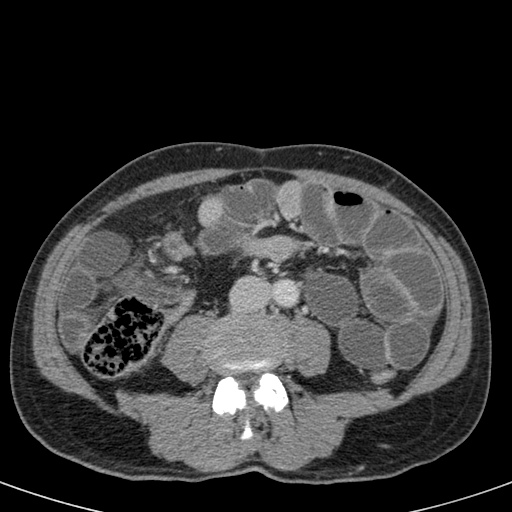
Slider image 36
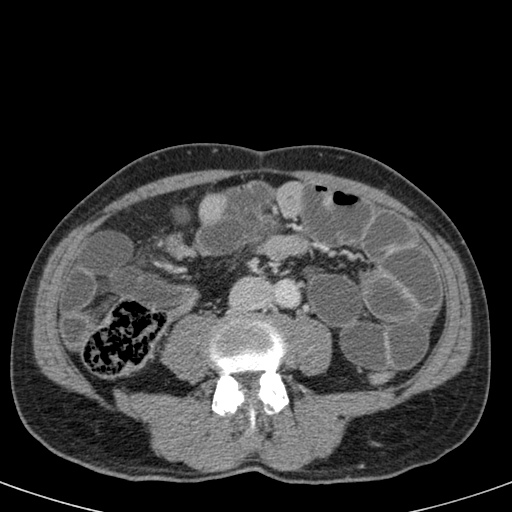
Slider image 37
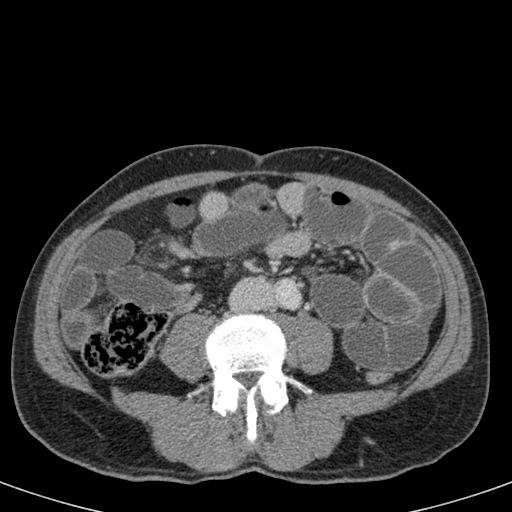
Slider image 38
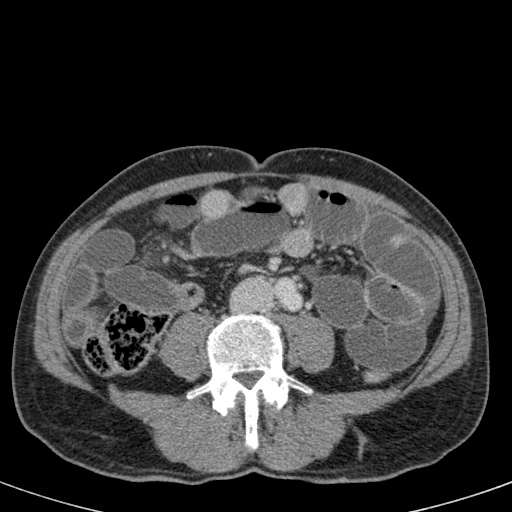
Slider image 39

Quai kín trong tắc ruột non
Ngày xuất bản
Tắc Ruột Non Dạng Quai Kín
Tắc Ruột Dạng Quai Kín
Tắc ruột dạng quai kín là một thể tắc ruột đặc biệt, trong đó hai điểm trên cùng một đoạn ruột bị tắc nghẽn tại một vị trí duy nhất, tạo thành một quai kín.
Nguyên nhân thường gặp là do dính ruột, xoắn mạc treo hoặc thoát vị nội.
Ở đại tràng, thể này được gọi là xoắn đại tràng (volvulus).
Ở ruột non, thể này đơn giản được gọi là tắc ruột non dạng quai kín.
Đặc biệt ở ruột non, nguy cơ thắt nghẹt và nhồi máu ruột rất cao với tỷ lệ tử vong từ 10-35%.
Ca lâm sàng tắc ruột non
Hãy bắt đầu với một ca lâm sàng khá khó, sau đó tiếp tục với một số kiến thức cơ bản về tắc ruột dạng quai kín.
Đây là một bệnh nhân bị tắc ruột non.
Cuộn qua các hình ảnh.
Bạn có thể tìm thấy quai kín và nguyên nhân gây ra nó không?
Khi tiếp nhận bệnh nhân tại phòng cấp cứu với biểu hiện nghi ngờ tắc ruột non (SBO), điều quan trọng nhất chúng ta cần làm, ngoài việc chẩn đoán xác định, là xác định sự hiện diện hay vắng mặt của tình trạng thắt nghẹt.
Thắt nghẹt được định nghĩa là tắc nghẽn kết hợp với tổn thương mạch máu.
Tỷ lệ bệnh suất và tử suất trong nhóm tắc ruột non chủ yếu do nhồi máu ruột và hoại tử ruột tiếp theo sau đó.
Nguyên nhân phổ biến nhất là tắc ruột dạng quai kín.
CT là phương pháp chẩn đoán hình ảnh được lựa chọn trong đánh giá bệnh nhân nghi ngờ tắc ruột non.
Hình ảnh CT của tắc ruột non dạng quai kín phụ thuộc vào hai yếu tố:
- chiều dài đoạn ruột tạo thành quai kín
- hướng của quai ruột so với mặt phẳng tạo ảnh
Nếu quai kín ngắn và nằm trong mặt phẳng tạo ảnh, chúng ta sẽ thấy quai ruột hình chữ U hoặc chữ C.

Tắc ruột dạng quai kín với các quai ruột giãn xếp theo hình nan hoa. Có dày thành ruột và phù nề mạc treo gợi ý thiếu máu cục bộ
Một hình ảnh quan trọng khác của tắc ruột dạng quai kín là các quai ruột non giãn xếp theo hình nan hoa với các mạch máu mạc treo hội tụ về một điểm trung tâm.
Hình ảnh này hầu như luôn do xoắn ruột non gây ra.
Các dấu hiệu thiếu máu cục bộ trong tắc ruột dạng quai kín tương tự như ở bệnh nhân thiếu máu mạc treo do các nguyên nhân khác:
- dày thành ruột
- phù nề mạc treo
- cổ trướng
- sự ngấm thuốc của thành ruột trong thiếu máu cục bộ có thể bình thường, tăng hoặc giảm.
Ca lâm sàng bên trái cho thấy một bệnh nhân khác bị tắc ruột dạng quai kín.
Mặc dù các mạch máu ngấm thuốc tốt, nhưng dường như thành ruột không ngấm thuốc.
Các dấu hiệu thiếu máu cục bộ khác trong ca này bao gồm phù nề mạc treo và dày thành ruột.
Ruột bị nhồi máu được phát hiện trong quá trình phẫu thuật.
Nếu quai kín dài hơn và định hướng vuông góc với mặt phẳng cắt, chúng ta sẽ thấy một cụm quai ruột như trong ca lâm sàng bên trái.
Đôi khi điều này khó nhận biết chỉ trên các lát cắt ngang và các tái tạo mặt phẳng coronal hoặc sagittal có thể hữu ích.
Trong ca này, cũng có phù nề mạc treo và cổ
Xoắn Ruột Già.
Bên trái là hình ảnh X-quang bụng thẳng của một nam bệnh nhân 57 tuổi với tiền sử đau bụng và chướng bụng tăng dần trong hai ngày.
Hãy quan sát hình ảnh trước rồi tiếp tục.
Ngoài hình ảnh giãn ruột lan tỏa, dấu hiệu chính trên phim này là một cấu trúc chứa khí lớn ở vùng chậu.
Chẩn đoán quan trọng cần nghĩ đến là xoắn đại tràng, và nhiều người sẽ chẩn đoán đây là xoắn đại tràng sigma do vị trí nằm ở vùng chậu.
Tuy nhiên, đây thực chất là xoắn manh tràng như sẽ được giải thích bên dưới.
Xoắn Manh Tràng
Xoắn ruột luôn lan rộng ra xa khỏi vị trí xoắn.
Do đó, xoắn đại tràng sigma chỉ có thể di chuyển lên trên và thường đi về phía góc phần tư trên bên phải.
Ngược lại, xoắn manh tràng có thể di chuyển đến hầu hết mọi vị trí và thậm chí có thể nằm ở vùng chậu (hình minh họa).
Bên trái là các hình ảnh CT bổ sung của cùng bệnh nhân nêu trên.
Hãy quan sát các hình ảnh này, tìm kiếm các dấu hiệu chính rồi tiếp tục.
Đầu tiên, chúng ta thấy đại tràng xuống xẹp và đại tràng lên không giãn, do đó đây không thể là xoắn đại tràng sigma.
Thứ hai, chúng ta thấy một cấu trúc hình mỏ chim ở góc phần tư dưới bên phải, đây là vị trí xoắn của ruột.
Ở góc phần tư dưới bên trái, chúng ta thấy manh tràng giãn.
Tái tạo ảnh mặt phẳng coronal có thể rất hữu ích trong việc thể hiện toàn cảnh tổn thương.
Bên trái, chúng ta thấy đại tràng lên và đại tràng xuống không giãn (mũi tên thẳng) và điểm chuyển tiếp của xoắn (mũi tên cong).
Xoắn manh tràng xảy ra do manh tràng xoắn quanh đại tràng lên, dẫn đến tắc ruột non.
Mạc treo ruột có nền hẹp và dài là yếu tố thuận lợi gây xoắn.
Xoay ruột giữa không hoàn toàn là một yếu tố nguy cơ.
Nhồi máu thường là hậu quả của ứ trệ tĩnh mạch, trong khi nguồn cung cấp động mạch hiếm khi bị ảnh hưởng.
Xoắn manh tràng chiếm khoảng 25% các trường hợp xoắn đại tràng.
Bên trái là hình ảnh điển hình của xoắn manh tràng.
Chúng ta có thể thấy vùng chuyển tiếp hình mỏ chim nằm ở góc phần tư dưới bên phải, cho thấy đây là xoắn manh tràng.
Manh tràng giãn nằm ở góc phần tư trên bên trái.
Cũng lưu ý đại tràng xuống xẹp nằm phía sau manh tràng giãn (mũi tên cong).
Các hình X-quang cho thấy hình ảnh điển hình của xoắn manh tràng.
Lưu ý rằng quai ruột giãn hướng về phía vùng xoắn, đây là vị trí mà manh tràng thường nằm.
Tiếp tục với các hình ảnh CT.
Cuộn qua các hình ảnh.
Các vùng xoắn và tắc nghẽn đã được đánh dấu.
Xoắn Đại Tràng Sigma
Bên trái là hình ảnh của một bệnh nhân bị xoắn đại tràng sigma.
Chúng ta có thể thấy đại tràng sigma giãn kéo dài từ vùng chậu lên tận góc phần tư trên bên phải.
Hãy quan sát hình ảnh và tự xác định tại sao đây không thể là xoắn manh tràng.
Sau đó tiếp tục.
Dấu hiệu then chốt là sự giãn của đại tràng đoạn gần.
Quai ruột giãn thấy ở bên trái chính là đại tràng ngang giãn.
Trên CT, chúng ta có thể thấy rõ vùng xoắn với đại tràng sigma kéo dài lên đến cơ hoành.
Đại tràng sigma là vị trí xoắn đại tràng thường gặp nhất.
Nó chiếm 75% các trường hợp tắc ruột già.
X-quang bụng tư thế nằm ngửa và đứng thẳng cho thấy dấu hiệu hạt cà phê đặc trưng trong xoắn đại tràng sigma.
Lưu ý rằng các quai ruột giãn hướng về phía vùng đại tràng sigma.
Tiếp tục với các hình ảnh CT.
Cuộn qua các hình ảnh.
Lưu ý điểm chuyển tiếp (mũi tên đỏ).
Đây là một trường hợp xoắn đại tràng sigma khác.
Trên X-quang bụng, rất khó nhận biết tình trạng bệnh lý vì có quá nhiều quai ruột giãn.
Tiếp tục với các hình ảnh CT.